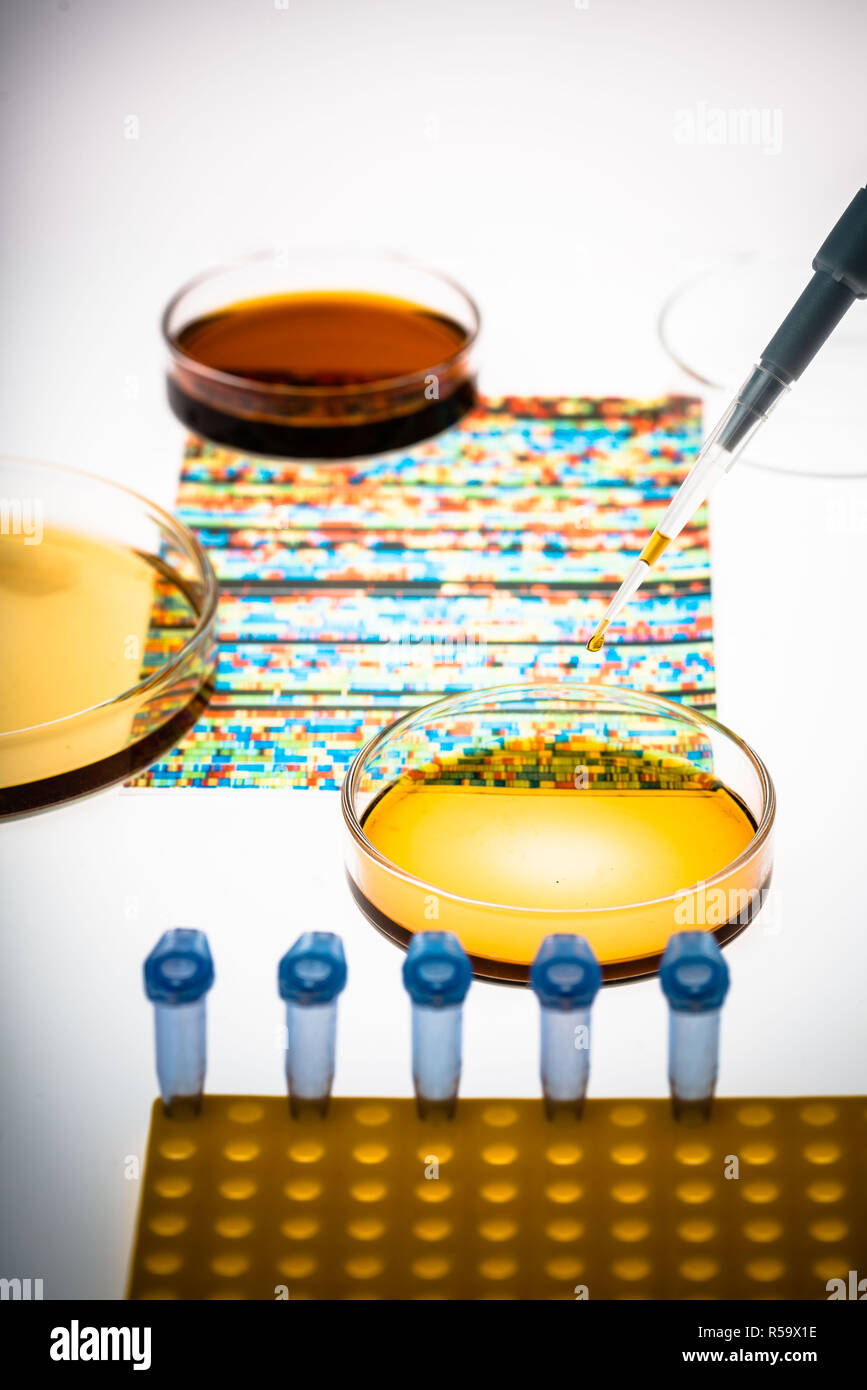
La ricerca genetica, immagine concettuale, DNA (acido desossiribonucleico) autoradiogramma e capsule di petri. Foto Stock

La ricerca genetica, immagine concettuale, DNA (acido desossiribonucleico) autoradiogramma e capsule di petri.
RMID:ID dell’immagine:R59X1E
Detagli dell'immagine
Collaboratore:
Phanie - Sipa PressID dell’immagine:
R59X1EDimensioni dei file:
116 MB (1,8 MB Download compresso)Liberatorie:
Modello - no | Proprietà - noMi occorre una liberatoria?Dimensioni:
5200 x 7796 px | 44 x 66 cm | 17,3 x 26 inches | 300dpiData acquisizione:
5 marzo 2015Fotografo:
Philippe Voisin